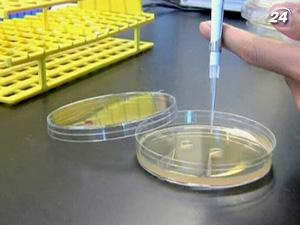
Американские ученые программируют бактерии

Более того, на горизонте все яснее вырисовываются новые беды - например, энергетический кризис, связанный с уменьшением природных запасов нефти и газа. Сторонники относительно молодого направления науки - синтетической биологии - стремятся решить эти проблемы.
В частности, специалисты Калифорнийского университета занимаются программированием бактерий. Цель - заставить микроорганизмы вести себя так, как нужно ученым.
"Мы пытаемся запрограммировать живую клетку так, как это делают с роботами или компьютерами. Единственное - мы программируем не одну клетку, а сразу несколько, формируя так называемые биоблоки. Они могут выполнять более сложные задачи, чем отдельные клетки", - рассказывает руководитель научной группы, доцент Калифорнийского университета Кристофер Войт.
Изобретатели уверяют, что запрограммированные бактерии пригодятся практически во всех сферах. К примеру, биоблоки помогут в выращивании разумной травы для производства биотоплива. Такие растения смогут подстраиваться под различные погодные условия, чтобы расти быстрее.
Также синтетические бактерии будут полезны в медицине. Например, они могут жить в организме человека и постоянно искать раковые клетки. В перспективе - создание специальных бактерий-убийц, которые смогли бы уничтожать злокачественные опухоли.
"Такие клетки ведут себя, как компьютер. То есть они воспринимают входные данные, выполняют соответствующие логические операции, а мы получаем результат. Со временем клетку можно будет полностью перепрограммировать, чтобы ввести новую информацию в существующий код. Главное, чего мы пытаемся достичь - это, чтобы биологические системы были такими же предсказуемыми, как электроника ", - говорит профессор биомедицинской инженерии, Бостонский университет Джеймс Коллинз.
Сколько лет понадобится ученым на реализацию своих замыслов - пока неясно. Но американцы полны оптимизма - за небольшой промежуток времени им удалось достичь гораздо больше, чем ожидалось первоначально.